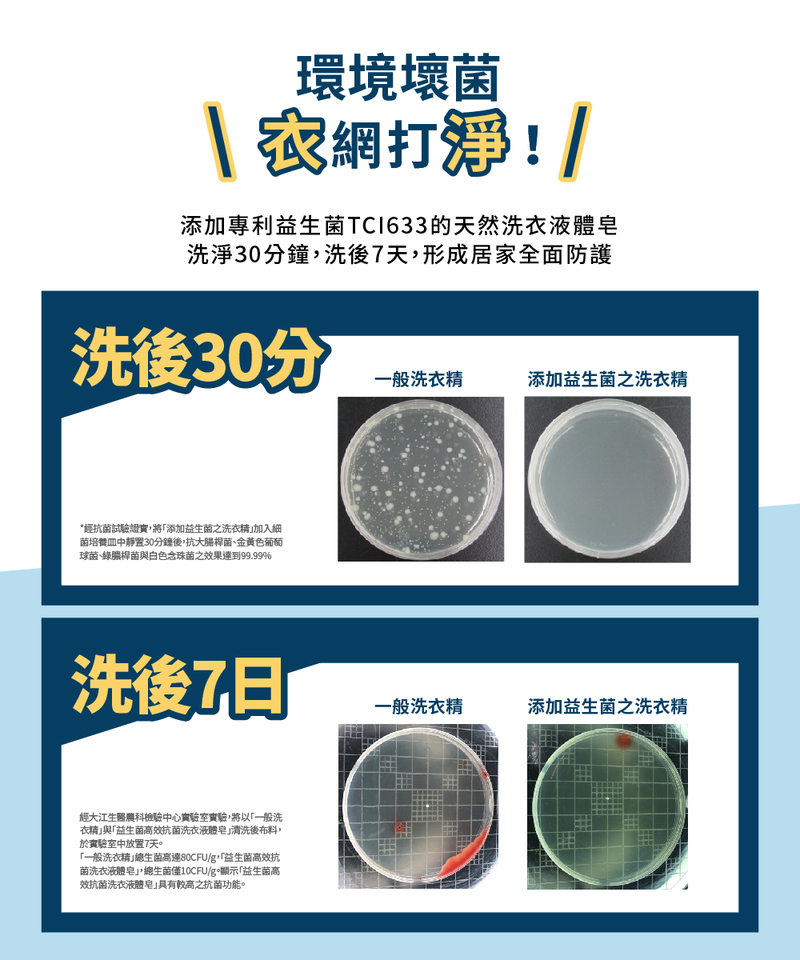

{{ 'fb_in_app_browser_popup.desc' | translate }} {{ 'fb_in_app_browser_popup.copy_link' | translate }}
{{ 'in_app_browser_popup.desc' | translate }}
{{ childProduct.title_translations | translateModel }}
{{ getChildVariationShorthand(childProduct.child_variation) }}
{{ getSelectedItemDetail(selectedChildProduct, item).childProductName }} x {{ selectedChildProduct.quantity || 1 }}
{{ getSelectedItemDetail(selectedChildProduct, item).childVariationName }}
■ 經美國P3等級實驗室(美國CDC認證實驗室)證實有效抗COVID-19變種新冠病毒>99.9%
■ 天然油脂製成液體皂,深層洗淨衣物
■ TCI633 益生菌抗菌科技,經intertek檢驗抗菌率>99%
■ 經Tentamus檢驗長效抗菌168小時
■ 紅石榴香氛,低泡沫、好沖洗、有效省水,直立&滾筒洗衣機皆適用
■ 美國雙認證~USDA綠色產品&AMA低敏認證
至2025-12-31T16:00:00.000+00:00截止 全店,12月消費滿999即享85折
至2025-12-31T16:00:00.000+00:00截止 全店,12月消費滿1299即享8折
至2025-12-31T16:00:00.000+00:00截止 全店,12月消費滿799即享9折
至2025-12-31T16:00:00.000+00:00截止 全店,12月消費滿399即享95折
至2026-01-01T04:00:00.000+00:00截止 指定分類,12月滿$1000贈皂力淨5效合1洗衣液補充包1600g
全店,全館消費滿$499超商免運費
全店,全館消費滿$599宅配免運費
商品存貨不足,未能加入購物車
您所填寫的商品數量超過庫存
{{'products.quick_cart.out_of_number_hint'| translate}}
{{'product.preorder_limit.hint'| translate}}
每筆訂單限購 {{ product.max_order_quantity }} 件
現庫存只剩下 {{ quantityOfStock }} 件